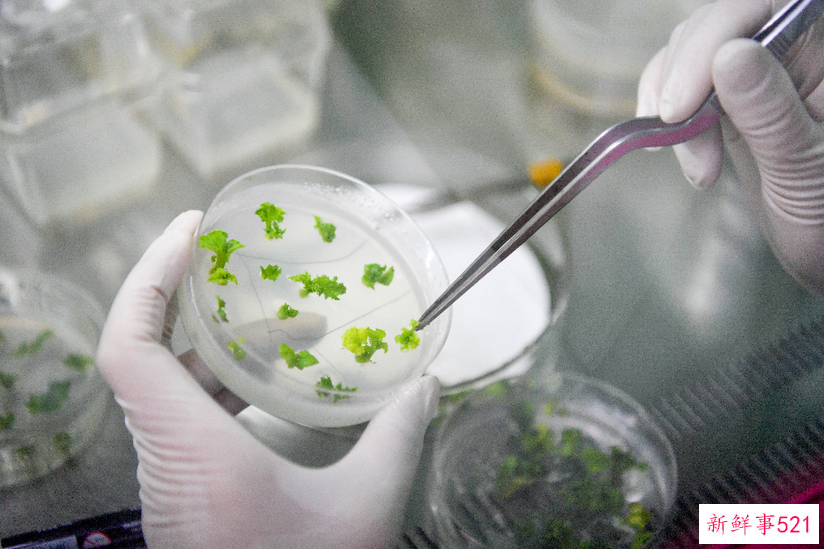
聚焦高质量发展｜一粒种，一颗“芯”——推进种业振兴的“天津行动”

微信扫码关注
微信扫码关注看新鲜资讯

 微信扫码关注
微信扫码关注
新华网天津3月17日电题:一粒种,一颗“芯”——推进种业振兴的“天津行动”
记者邵香云、白佳丽
在天津市农作物种质资源库,科研人员王璐将一份合格的种子“包装”进铝箔袋中,贴好二维码“身份证”后,小心封存;
在天津市武清区小麦育种试验田里,育种家时晓伟蹲在田里观察着春小麦出苗情况,她参与新培育的5个强筋高产小麦品种正在参加区域试验;
在天津市宁河区的农作物种植专业合作社,农民李桂元正忙着与老乡们讨论今年小站稻的种植计划,他期待优势良种再次打破去年的亩产纪录……
春耕时节,津沽大地的田野上,育种人正开始新一年的忙碌。擘画发展蓝图,保护种质资源,选育自主品种,赋能产业发展……瞄准农业“芯片”,天津正奋力书写种业振兴的新答卷。
保护,为了一粒好种子
在天津市农科院,有一座特别的“种子银行”——天津市农作物种质资源库,这里保存着来自不同地区、不同年代的4.7万余份种质资源。
“有的是育种家历经漫长岁月培育而成,有的是在农民手中代代相传、留存下来,有的是科研工作者跋山涉水采集而来,十分珍贵。”在这里工作的“90后”王璐小心翼翼地呵护着每一份种子。
在这座颇具科幻色彩的“种子银行”,王璐这样解释精心保存它们的原因,“科研人员培育一粒好种子,必须有好的育种材料,也就是种质资源。种质资源是生物携带遗传信息的载体,具有实际或潜在利用价值,农作物种质资源是农业科技原始创新、现代种业发展的基石。”

天津市农科院种质资源与生物技术研究所拍摄的种质资源库内景。(新华社记者孙凡越摄) 过去,不少种质资源分散在育种家、农民、企业手中,一些种质资源甚至面临遗失风险。国家大宗蔬菜产业技术体系花椰菜品种改良岗位专家、天津市农科院研究员孙德岭最能体会到保存一粒种的“难”。
十多年前,由于条件有限,孙德岭与同事们选育出的种子存放在单位冷柜中。没想到碰上断电,孙德岭发现时,培育了十多年的种子早已发了霉。这位极富经验的育种专家“两眼一黑”,难过了许久。
推动种业振兴,种质资源保护是基础。为了更好地保存珍贵的、有地方特色的种质资源,2019年,天津决定建设一座贮存能力达40万份的种质资源库,并于去年10月正式运行。王璐说,有了这座种质资源库,一些资源甚至能够有效保存15年之久。

王璐正在天津市农作物种质资源库工作。(新华社记者孙凡越摄) “心在资源库,人在田野里”,是同事们对天津市农科院种质资源与生物技术研究所工程师徐石勇的描述。与王璐不同,他的工作是开展农作物种质资源的扩繁更新、精准鉴定,为种业科研的核心突破打下基础。
在天津市西青区辛口镇的扩繁基地大棚里,徐石勇认真地记录着每一份种质资源的长势。“这些都是被育种家或市场‘抛弃’的种子。”徐石勇说,为了保护生物多样性、留存更多育种资源,今年他从种质资源库中筛选出了330个数量较少的老品种进行扩繁,包括丝瓜、白菜、萝卜、黄瓜等,以备今后的育种需要。
天津还出台《天津市种业振兴行动实施方案》,加大种源保护力度。如今,10个涉农区农作物种质资源普查和2610家养殖场畜禽水产种质资源普查全部完成,审定登记农作物新品种96个,获得植物新品种授权的品种56个。除天津市农作物种质资源库外,天津市鲤鲫鱼水产种质资源场也建成并投入使用。
“未来,天津种质资源库将做到应收尽收、应保尽保,从种质资源收集、保护到种质资源的挖掘和利用,从基础研究、关键技术的攻关到新品种的选育,为天津种业振兴赋能,为中国饭碗装上更多更好的天津粮、天津菜贡献力量。”天津市农科院院长程奕说。
创新,攥紧农业“芯片”
在耕地资源相对有限的天津,如何端牢“中国饭碗”?20多年前,刚刚从西北农林科技大学毕业的时晓伟,怀着一腔热爱,开始在津沽的土地上寻找属于她的答案。
“当时,国内的强筋小麦需求较大,但大部分却要依靠进口。即使有小规模种植,也达不到收购企业的要求。”天津市农科院农作物研究所育种专家时晓伟回忆。
优质小麦的短缺,制约着彼时我国小麦产业的发展。读书时就从事小麦育种研究的时晓伟,敏锐地抓住这一点,利用天津的气候优势,开始和同事们进行探索性尝试。

在天津市农科院,时晓伟(右)与课题组同事工作交流。(新华社记者孙凡越摄) “刚开始时非常不顺利,种质资源的缺乏就先给了我们一个‘下马威’。”时晓伟说,通过广泛搜集,团队筛选出了强筋小麦资源CSR17,并以此为基础开始尝试培育。
之后的两年时间,时晓伟大都泡在实验室和田间,看着小麦拔节又抽穗。终于,她精心培育的品种作为特用品种通过审定,定名为“津强1号”。
“品质太好了,完全可以替代进口。”时晓伟听到这句话时,喜极而泣。之后的20多年,团队不断提升强筋小麦品种的产量、抗病性等,成功育出了15个强筋高产小麦品种,覆盖天津、河北、内蒙古等地,累计种植面积达1000多万亩,原粮每公斤售价比普通小麦高出10%到15%左右。
一颗颗滚落在田间的汗珠,记录着成功背后的不易。早年因为没有小麦品质分析仪器,她与同事们只能靠牙齿咀嚼麦粒,再用拇指与食指测试面筋黏弹性。
“一天嚼下来,下颌骨都疼!可以说,‘津强5号’与‘津强6号’获得天津市科技进步一等奖,是我们用嘴巴完成的品质初步鉴定。”时晓伟说。
“春争日,夏争时”,是时晓伟常常挂在嘴边的话,总带着一种紧迫感的她,在育良种的同时也开始探索“寻良方”。
为缩短选育时间,时晓伟与同事们改良了传统的小麦育种方法,在云南昆明、云南元谋建设了两个新的育种基地,利用三地不同的时空与气候差异进行穿梭育种,使传统的小麦育种从组配杂交组合到世代稳定的6年六代,缩短为3年八代,显著提高了育种进程和新品种选育质量。
创新,是时晓伟寻找的答案,更是天津种业振兴的一个缩影。天津市农业农村委员会种业管理处处长齐志伟介绍,近年来,天津强化“蔬菜种质创新国家重点实验室”等平台建设,加大财政支持力度,多方筹集资金支持科技创新和人才引进,种业创新基础进一步夯实。

天津市农科院种质资源与生物技术研究所组培室拍摄的花椰菜基因编辑再生植株。(新华社记者孙凡越摄) 种源自主可控,关键在种业科技自立自强。稻种“闯”出一片天,强筋春小麦品种可替代进口,花椰菜品种打破国外垄断并走出国门……“天津已形成以黄瓜、花椰菜等品种为主导的优势种业,‘夏雪’等菜花品种还出口到巴基斯坦、印度等国,种羊、种鱼、种猪等畜牧水产育种不断取得新突破。”天津市农业农村委员会种植业管理处处长王学忠说。
赋能,让产业做大做强
从国外留学归来,张建芳选择回到家乡天津市宁河区,做了一名“新农人”。投身广阔的农村天地,这个年轻的女孩有了更清晰的方向。“宁河人均耕地面积排全市第一,小站稻又是我国有名的优质水稻,我要把这两个亮点结合起来。”张建芳说。
原产于天津的小站稻,在清末声名远播,后因天津水量减少而衰落。2018年,天津提出《天津小站稻产业振兴规划(2018-2022年)》,一场“水稻研发升级行动”打响。连续多年,天津市农业农村委员会组织科研部门先后选育并审定通过了多个水稻品种。

张建芳正在检查产品。(新华社记者孙凡越摄) 2020年,张建芳成为天津小站香米业有限公司的总经理,并精心选中了亩产高、口感好的小站稻优质品种之一“金稻919”,播撒在了流转来的300多亩土地上。
“当时‘金稻919’面市不久,一些稻农不敢做‘第一个吃螃蟹的人’,但我相信好种子能帮我们打开销路。”张建芳说。
从育秧、插秧、收割到打包、发货,张建芳从头学起,经过3年多的发展,已尝试种植多个小站稻新品种,与农户的订单种植面积也扩大到5万亩。好种子带来的好品质,让她生产的大米广受好评,2700余户农民在她的带动下增收致富。
家住宁河区大北涧沽镇大北涧沽村的李桂元,就是张建芳的“订单户”。种地40多年,他在当地成立了天津市兄弟联合农作物种植专业合作社,种植水稻面积达上千亩。
“我们跟张建芳合作,种出来的水稻亩产量能到1500斤左右,一亩地能多赚200元,”李桂元喜上眉梢,“看着我们的收成好,去年全村的水稻种植面积已经扩大到了1300多亩。”
在天津市农科院,科研人员正开展黄瓜遗传转化筛选试验。(新华社记者孙凡越摄) 近年来,天津围绕农业全产业链,以优势良种为牵引,打造了小站稻、蔬菜、畜牧、水产、林果等重点产业,积极谋划现代农业产业园、农业产业强镇,壮大了一批种业振兴骨干企业。
天津市农业农村委员会乡村产业发展处处长刘军介绍,“天津奥群牧业有限公司成为国家育种攻关十大优势企业之一,承担国家肉羊育种自主攻关任务;科润公司牵头承担国家黄瓜联合育种攻关任务;小站稻良种覆盖率达到100%。”
“今年中央一号文件提出,深入实施种业振兴行动。天津市乡村振兴全面推进行动方案对加快种业振兴作了专门部署,我们将扎实落实各项任务,筑牢粮食安全和农业高质量发展的种业根基。”天津市农业农村委员会党委书记、主任金汇江说。(完)
记者:邵香云、白佳丽
海报:方金洋、冯娟
新华社天津分社
(新华网)
推荐阅读

女人裙底下的风光
夏天到了,你是否很好奇女人的裙底,夏天是很多男人的福利,不过大部分女人都是有穿内裤,因此裙底也是内裤,也不排除有些女的可能主人任务或是刚被操完,内裤没有穿。昨天约狼嫂车震,原本要把她丁字裤扣留下来,担
2026-03-12

三上悠亚开箱爱马仕遭酸「靠裸体买来炫耀」 本人霸气反击
三上悠亚开箱爱马仕遭酸靠裸体买的,钓出她霸气反击。(资料图/陈俊吉摄)日本女星三上悠亚凭借甜美外型及魔鬼身材,深受许多粉丝喜爱,除了演艺事业外,近年也将自创品牌经营得有声有色。然而,她日前拍影片分享自
2026-03-12

女人来大姨妈前后,欲望最强,甚至会主动
女人由于生理构造不同,在来大姨妈前后的时间里,受激素控制,欲望特别强。强到什么地步?人有不同,各有各的想法和做法。下面我来分享一下。我一个姐姐,48岁,姨妈正常就是少,但不知怎的,这两年她姨妈前后的欲望比
2026-03-08

狂野裸模毛明 入选中国时尚媒体发布的"中国十大裸模"榜单,
毛明(1992年-),中国女模特,吉林籍,身高168cm,2012年以人体模特身份进入模特行业。其艺术风格以"狂野派"著称,同年入选中国时尚媒体发布的"中国十大裸模"榜单,并被评价为"模特界一颗新星" 。因为她的胸部很圆润饱满,
2026-03-08

国模开山鼻祖汤加丽 人体艺术跟情色就是一纸之隔 而且纸很
汤加丽是国内裸模的破冰者,称她为摄影人体艺术模特的开山鼻祖也并不过份,她作为第一个裸模,与后来汤芳和张筱雨的道路有很大的不同。不说什么社会反响,道德伦理方面的问题,先总结以下不同之处,纯个人观点:一是
2026-03-08
推荐文章